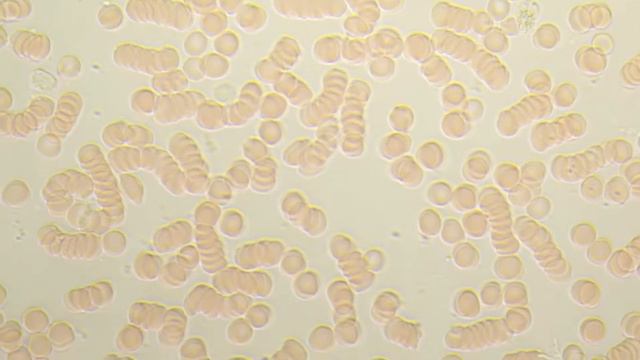
Состояние крови после употребления растительного сыра по собственной технологии смотреть онлайн

Автор / Канал: Природные декорации Страница 10

"Факел", 25 отряд, лето 2019г

Как связать поводки одинаковой длинны.

Made with Michigan Hands: Motif Jewelers

Умба 12 июня 2016 года 550 лет. Поморские частушки.

Odell Beckham Jr |"Lightyear"| OBJ Motivation/Highlights ᴴᴰ

ยกยอดพลูปีกนกด่าง monstera karstenianum variegated

Эрик и Наталья Райнер. Роза чайная.

Серия домашних матчей хоккейного клуба «Адмирал» началась удачно
Состояние крови после употребления растительного сыра по собственной технологии

Свадебный букет для Анастасии. Wedding bouquet for Anastasia.

Pacquiao vs Barrera 2 | October 6, 2007

Прохождение Call of duty MW 1 R (7)

Финальные частушки Рождественской встречи, январь 2017 г.

Отзывы об отдыхе Турции 2018 г

Целый лес цветоносов на орхидея.

Фитнес-тур World Class Австрия/Франция

Обзор Review Gamo Replay 10 Magnum 4.5 mm. (177 cal.)

Eric Saade - Coming Home (acoustic)
![Call of Duty Modern Warfare 3 multiplayer gameplay [PC][Plutonium IW5] смотреть онлайн Call of Duty Modern Warfare 3 multiplayer gameplay [PC][Plutonium IW5] смотреть онлайн](https://pic.rtbcdn.ru/video/6f/99/6f99802696611571680a5249651525ee.jpg)
Call of Duty Modern Warfare 3 multiplayer gameplay [PC][Plutonium IW5]
![Жара [4K UHD] Call of Duty Modern Warfare - Remastered Прохождение #11 смотреть онлайн Жара [4K UHD] Call of Duty Modern Warfare - Remastered Прохождение #11 смотреть онлайн](https://static.rutubelist.ru/static/img/default-music.png)
Жара [4K UHD] Call of Duty Modern Warfare - Remastered Прохождение #11

Oberhof-2017. Comments from Arnd Peiffer after his 2nd place in pursuit

Русь изначальная.

mendota megacross helmet cam backwards

HowToTalk 007 - Nils-Eric Johansson, Mia Åslander
За каждым успешным каналом стоит личность, идея и сотни часов кропотливого труда. Если вы здесь, значит, автор «Природные декорации» уже сумел зацепить ваше внимание своим уникальным стилем или подачей. А мы на RUVIDEO позаботились о том, чтобы вы могли изучить весь архив его работ в максимально комфортных условиях — без лишней суеты и преград.
Почему за работами канала «Природные декорации» так интересно наблюдать? Всё просто: это честный контент, который находит отклик в сердцах зрителей. На нашем ресурсе вы можете смотреть онлайн все видео любимого автора бесплатно и в хорошем качестве. Нам важно, чтобы вы видели каждую деталь и слышали каждый нюанс, поэтому мы используем только стабильные плееры из открытых источников Rutube.
Следите за новинками канала, пересматривайте старые шедевры и открывайте для себя новые грани творчества «Природные декорации». Мы постоянно обновляем ленту, чтобы у вас под рукой всегда были самые свежие выпуски. Никаких сложных регистраций — только вы и творчество, которое вдохновляет. Приятного вам путешествия по миру авторского контента на RUVIDEO!
Видео взято из открытых источников Rutube. Если вы правообладатель, обратитесь к первоисточнику.